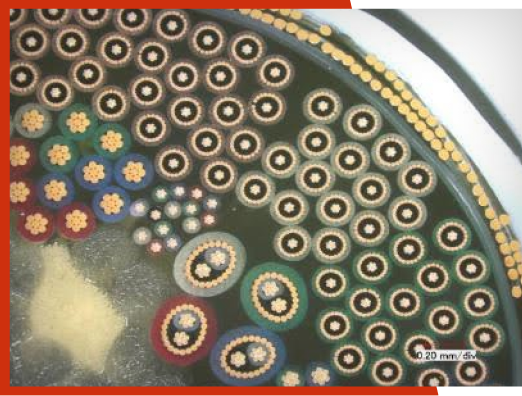

Proterial Cable America High Performance Medical Solutions (PCA-HPMS) designs and manufactures high-performance medical cable and assemblies for ultrasound, endoscopy, sensors, catheters, and surgical robotics. Our expertise in micro-coaxial technology, advanced materials, and precision engineering ensures exceptional signal quality, flexibility, and durability for critical medical applications.
With ISO 13485:2016-certified manufacturing and advanced testing capabilities, PCA-HPMS delivers industry-leading solutions that meet the most stringent medical standards.
PCA-HPMS offers an extensive range of fine wire and custom cable solutions designed to meet the highest industry standards.
PCA-HPMS micro-coaxial cable is built for a wide array of precision medical equipment and cabling applications requiring superior signal integrity in a space-saving configuration. Highly reliable for maintaining stable capacitance, these cables are necessary for ultrasound probes, catheters, and endoscopic imaging devices.
Expand the tables for High, Low, and Solid Conductor Micro-Coaxial Cable below to request a sample or quote!
Choose your parts from the table below by clicking “Add to Request” for each desired part. Once all parts have been selected, please click ‘Request a Sample or Quote’ to complete the request. Please note: sample requests are limited to typical sample sizes. Any orders above the sample size may incur an additional cost. Our team reviews all requests, and final details will be confirmed with you after submission.
We offer a broad selection of copper alloy wire in precision wire gauges ranging from 36 AWG to 50 AWG. These superfine, high-strength, highly conductive 7-strand constructions are useful for small-diameter flexible cables. We also offer standard 50 and 60-ohm impedance products. Contact us if alternate constructions are required.
| Coaxial Product Number | Sample Inventory Available | Amount in Stock (100m Increments) | Actions | AWG Stranding | Material | Conductor DCR@20⁰C Ω/kft / (Ω/km) | Insulation Material | Shield Material | Jacket Material | Jacket Diameter | Capacitance pF/ft (pF/m) | Impedance @10MHz (Ω) |
| 5361-110 | Yes | 2200 | 36 (7/44) (7/0.05 mm) | Tinned Copper | 479 (1,569) | PFA = Perfluoroalkoxy | Tinned Copper | PFA = Perfluoroalkoxy | 0.021 (0.54) | 33.6 (110) | 50 | |
| 5381-110 | Yes | 700 | 38 (7/46) (7/0.04 mm) | Tinned Copper Alloy | 1,007 (3,300) | PFA = Perfluoroalkoxy | Tinned Copper | Polyester Tape | 0.017 (0.44) | 33.6 (110) | 50 | |
| 5401-110 | Yes | 1100 | 40 (7/48) (7/0.031 mm) | Tinned Copper Alloy | 1,525 (5,000) | PFA = Perfluoroalkoxy | Tinned Copper Alloy | Polyester Tape | 0.013 (0.32) | 33.6 (110) | 50 | |
| 5411-110 | No | 0 | 41 (7/49) (7/0.028 mm) | Silver Plated Copper Alloy | 1,525 (5,000) | PFA = Perfluoroalkoxy | Tinned Copper Alloy | Polyester Tape | 0.012 (0.31) | 33.6 (110) | 50 | |
| 5421-110 | Yes | 500 | 42 (7/50) (7/0.025 mm) | Silver Plated Copper Alloy | 2,227 (7,300) | PFA = Perfluoroalkoxy | Tinned Copper Alloy | Polyester Tape | 0.011 (0.29) | 33.6 (110) | 50 | |
| 5431-110 | No | 0 | 43 (7/51) (7/0.023 mm) | Silver Plated Copper Alloy | 2,288 (7,500) | PFA = Perfluoroalkoxy | Tinned Copper Alloy | Polyester Tape | 0.011 (0.27) | 33.6 (110) | 50 | |
| 5441-110 | Yes | 100 | 44 (7/52) (7/0.02 mm) | Silver Plated Copper Alloy | 3,203 (10,500) | PFA = Perfluoroalkoxy | Silver Plated Copper Alloy | Polyester Tape or PFA | 0.010 (0.24) | 33.6 (110) | 50 | |
| 5451-110 | No | 0 | 45 (7/53) (7/0.018 mm) | Silver Plated Copper Alloy | 3,752 (12,300) | PFA = Perfluoroalkoxy | Silver Plated Copper Alloy | Polyester Tape or PFA | 0.009 (0.22) | 33.6 (110) | 50 | |
| 5461-110 | No | 0 | 46 (7/54) (7/0.016 mm) | Silver Plated Copper Alloy | 4,728 (15,500) | PFA = Perfluoroalkoxy | Silver Plated Copper Alloy | PFA = Perfluoroalkoxy | 0.008 (0.20) | 35.1 (115) | 50 | |
| 5461-115 | Yes | 200 | 48 (7/56) (7/.012) | Silver Plated Copper Alloy | 7,010 (23,000) | PFA = Perfluoroalkoxy | Silver Plated Copper Alloy | PFA = Perfluoroalkoxy | 0.007 (0.17) | 38.1 | 50 | |
| 5501-125 | Yes | 300 | 50 (7/58) (7/0.01 mm) | Silver Plated Copper Alloy | 11,430 (37,500) | PFA = Perfluoroalkoxy | Silver Plated Copper Alloy | PFA = Perfluoroalkoxy | 0.006 (0.15) | 38.1 (125) | 50 | |
| 5481-120 | Yes | 800 | 48 (7/56) (7/.012) | Silver Plated Copper Alloy | 7,010 (23,000) | PFA = Perfluoroalkoxy | Silver Plated Copper Alloy | PFA = Perfluoroalkoxy | 0.007 (0.17) | 38.1 | 50 |
Choose your parts from the table below by clicking “Add to Request” for each desired part. Once all parts have been selected, please click ‘Request a Sample or Quote’ to complete the request. Please note: sample requests are limited to typical sample sizes. Any orders above the sample size may incur an additional cost. Our team reviews all requests, and final details will be confirmed with you after submission.
Proterial Cable America’s advanced foam PFA extrusion process delivers reliable low-capacitance cable performance. We utilize a polyester tape skin over the foam to deliver the dielectric to withstand the high voltage the medical industry requires. 38 AWG to 48 AWG wire sizes are available. These are 70, 75, and 85 Ohm impedance cables.
| Coaxial Product Number | Sample Inventory Available | Amount in Stock (100m Increments) | Actions | Inner Conductor- AWG (Stranding) | Inner Conductor – Material | Conductor DCR@20°C Ω/kft (Ω/km) | Insulation Material | Shield Material | Jacket Material | Jacket – Diameter – Inch (mm) | Capacitance pF/ft (pF/m) | Impedance @10Mhz (Ω) |
| 5381-060 | No | 0 | 38 (7/46) (7/0.04 mm) | Silver Plated Copper Alloy | 1,007 (3,300) | Cellular PFA (+Polyester tape skin) | Tinned Copper Alloy | Polyester Tape | 0.021 (0.54) | 18.3 (60) | 75 | |
| 5401-060 | No | 0 | 40 (7/48) (7/0.03 mm) | Silver Plated Copper Alloy | 1,525 (5,000) | Cellular PFA (+Polyester tape skin) | Tinned Copper Alloy | Polyester Tape | 0.016 (0.41) | 18.3 (60) | 75 | |
| 5411-060 | No | 0 | 41 (7/49) (7/0.028 mm) | Silver Plated Copper Alloy | 1,525 (5,000) | Cellular PFA (+Polyester tape skin) | Tinned Copper Alloy | Polyester Tape | 0.014 (0.36) | 18.3 (60) | 75 | |
| 5421-060 | Yes | 800 | 42 (7/50) (7/0.025 mm) | Silver Plated Copper Alloy | 2,227 (7,300) | Cellular PFA (+Polyester tape skin) | Tinned Copper Alloy | Polyester Tape | 0.013 (0.34) | 18.3 (60) | 75 | |
| 5431-060 | No | 0 | 43 (7/51) (7/0.023 mm) | Silver Plated Copper Alloy | 2,288 (7,500) | Cellular PFA (+Polyester tape skin) | Tinned Copper Alloy | Polyester Tape | 0.012 (0.31) | 18.3 (60) | 75 | |
| 5441-060 | No | 0 | 44 (7/52) (7/0.02 mm) | Silver Plated Copper Alloy | 3,203 (10,500) | Cellular PFA (+Polyester tape skin) | Tinned Copper Alloy | Polyester Tape | 0.011 (0.28) | 18.3 (60) | 75 | |
| 5461-060 | Yes | 500 | 46 (7/54) (7/0.016 mm) | Silver Plated Copper Alloy | 4,728 (15,550) | Cellular PFA (+Polyester tape skin) | Tinned Copper Alloy | Polyester Tape | 0.01 (0.25) | 18.3 (60) | 75 | |
| 5481-070 | No | 0 | *48 (7/56) (7/0.013 mm) | Silver Plated Copper Alloy | 7,010 (23,000) | PFA with Airspace Aperture (+Polyester tape skin) | Silver Plated Copper Alloy | Polyester Tape | 0.008 (0.21) | 21.4 (70) | 70 |
Choose your parts from the table below by clicking “Add to Request” for each desired part. Once all parts have been selected, please click ‘Request a Sample or Quote’ to complete the request. Please note: sample requests are limited to typical sample sizes. Any orders above the sample size may incur an additional cost. Our team reviews all requests, and final details will be confirmed with you after submission.
Proterial Cable America’s solid conductor constructions combine all the attributes of stranded wire coaxials while offering a slightly smaller diameter, improved current carrying capacity, and lower loss.
Features and Benefits:
| Coaxial Product Number | Inner Conductor – AWG (Solid) | Inner Conductor – Material | Actions | Conductor DCR@20°C Ω/kft (Ω/km) | Insulation – Material | Shield – Material | Jacket – Material | Jacket – Diameter Inch (mm) | Capacitance Pf/ft (pF/m) | Impedance@10MHz (Ω) |
| 5403-110 | 40 (1/40) (1/0.08 mm) | Silver Plate Copper Alloy | 1,372 (4,500) | PFA | Silver Plated Copper Alloy | Polyester Tape (0.02 mm Thick) | 0.013 (0.33) | 33.6 (110) | 50 | |
| 5423-110 | 42 (1/42) (1/0.064 mm) | Silver Plate Copper Alloy | 2,134 (7,000) | PFA | Silver Plated Copper Alloy | Polyester Tape (0.02 mm Thick) | 0.011 (0.274) | 33.6 (110) | 50 | |
| 5443-110 | 44 (1/44) (1/0.051 mm) | Silver Plate Copper Alloy | 3,353 (11,000) | PFA | Silver Plated Copper Alloy | Polyester Tape (0.02 mm Thick) | 0.009 (0.221) | 33.6 (110) | 50 | |
| 5463-115 | 46 (1/46) (1/0.040 mm) | Silver Plate Copper Alloy | 5,395 (17,700) | PFA | Silver Plated Copper Alloy | Polyester Tape (0.02 mm Thick) | 0.007 (0.19) | 35.1 (115) | 50 | |
| 5483-120 | 48 (1/48) (1/0.030 mm) | Silver Plate Copper Alloy | 9,601 (31,500) | PFA | Silver Plated Copper Alloy | Polyester Tape (0.02 mm Thick) | 0.006 (0.156) | 36.6 (120) | 50 | |
| 5503-125 | 50 (1/50) (1/0.025 mm) | Silver Plate Copper Alloy | 13,868 (45,500) | PFA | Silver Plated Copper Alloy | Polyester Tape (0.02 mm Thick) | 0.005 (0.139) | 38.1 (125) | 50 |
| Composition | Breakdown Tensile Strength (Mpa) | Electrical Conductivity (%IACS) | Bending Repetitions (# Times) | |
| NN (Proterial Standard) | Cu-0.19% Sn-0.20% In | 890 | 76 | 1.2×10⁴ |
| S-MF-AG* Proterial-High Performance | Cu-2.0 % Ag | 950 | 85 | 1.2×10⁴ |
| Conventional Industry Alloy A | Cu-0.3 % Sn | 875 | 73 | 1.1×10⁴ |
| Conventional Industry Alloy B | Cu-0.8 % Cr | 460 | 90 | 6.0×10⁴ |
| AWG Size | Conductor (Strands/Wire Dia. Um) | Standard Conductor Resistance (ohm/km) NN | Standard Conductor Resistance (ohm/km) S-MF-AG |
| 43 | 43 (7/51) (7/0.023 mm) | 7,500 | 6,700 |
| 44 | 44 (7/52) (7/0.20mm) | 9,800 | 8,900 |
| 45 | 45 (7/53) (7/0.018 mm) | 12,300 | 11,000 |
| 46 | 46 (7/54) (7/0.016 mm) | 15,500 | 14,000 |
| 48 | 48 (7/56) (7/0.012 mm) | 23,700 | 21,500 |
| 50 | 50(7/58) (7/0.10 mm) | N/A | 35,500 |

Our twisted pair cable provides reliable, high-speed data transmission while reducing electromagnetic interference (EMI). Twisted pairs reduce noise through differential signaling. They are effective for use in diagnostic equipment and advanced imaging devices.
PCA-HPMS high-performance ultrasound cables are engineered to deliver exceptional signal integrity, flexibility, and durability for medical imaging applications. PCA-HPMS micro-coax and bundled cable designs ensure low capacitance, high sensitivity, and great impedance control, making them ideal for ultrasound probes, medical imaging systems, diagnostic equipment and NDT applications.


PCA-HPMS offers ultra-thin wire. These wires can be bundled for use in ultrasound, as well as other devices such as catheters, endoscopes, vital instruments like surgical tools, and diagnostic equipment.
SilMED® non-sticky silicone cable is a proprietary medical-grade silicone cable designed for enhanced handling, longevity, and performance in medical device applications like umbilicals for endoscopy, catheters, and ultrasound probes.
Medical OEMs worldwide trust PCA-HPMS as their medical cable manufacturer. Our high-performance, custom medical cable solutions and rigorous quality management system ensure precision, durability, and reliability. With a wide range of tailored designs, ISO 13485:2016-certified facilities, and deep industry expertise, PCA-HPMS delivers advanced cable solutions for virtually any medical device application, including ultrasound, endoscopy, catheters, and surgical robotics.
Partner with PCA-HPMS to develop your next-generation medical wire solutions.
Samples are available in 1m increments, up to 5m. Quotes are available for larger orders, available in 100m increments, subject to availability.